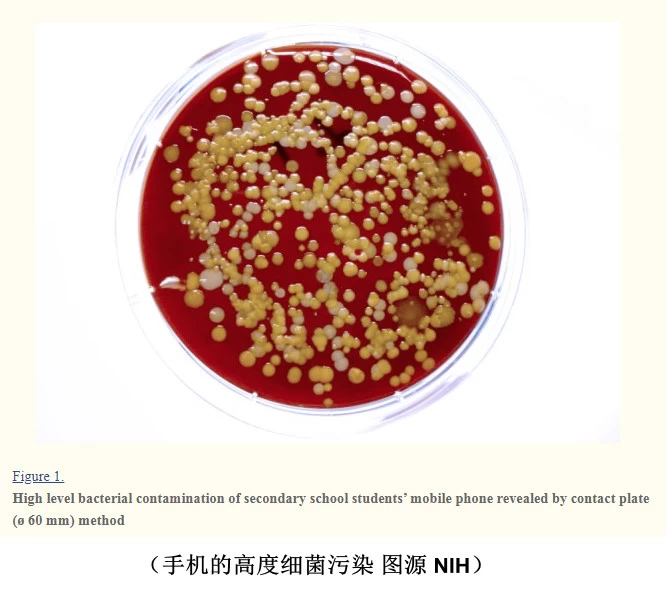

太可怕了!别让手机成为病毒载体
2020-02-03 18:21:21AI云资讯1536

一场突如其来的疫情,让这个春节多了一些关键词——武汉、新型冠状病毒、口罩、隔离……
从去年年底发现确诊病例到今天,一个多月的时间疫情一直处于扩散阶段。那么,这场突然爆发的新型冠状病毒肺炎是如何发生和传播的?我们使用最为频繁的手机又为什么会成为病毒载体?
什么是新型冠状病毒
冠状病毒是一大类病毒,冠状病毒是一大类常见于动物的病毒。据美国疾病控制和预防中心称,在极少数情况下,它们是科学家所称的人畜共患疾病,也就是说它们可以从动物传染给人类。
这种病毒能使人生病,通常是轻微(或中度)上呼吸道疾病,类似于普通感冒。冠状病毒的症状包括流鼻涕、咳嗽、喉咙痛,可能是头痛,也可能是发烧,持续几天。对于那些免疫系统弱的人,老年人和非常年轻的人来说,病毒有可能引起一种较低、更严重的呼吸道疾病,如肺炎或支气管炎。有一些人类冠状病毒已知是致命的。中东呼吸综合征(Middle East Respiratory Syndrome,简称MERS病毒)于2012年在中东首次报道,也会引起呼吸系统问题,但这些症状要严重得多。疾控中心称,每10名感染MERS的患者中就有3至4人死亡。

香港大学研究人员于1月31日公布首批新型冠状病毒在细胞内复制过程的图像。通过新型冠状病毒的薄片电子显微图像显示,病毒粒子从受感染细胞的表面释放出来,每个受感染的细胞会衍生出数以千计的病毒粒子,从而继续感染新细胞。
传播途径
冠状病毒可能的传播途径有三个:一是通过咳嗽或打喷嚏在空气传播;二是与病人的密切接触;三是触摸被污染的物体表面,然后用脏手触碰嘴巴、鼻子或眼睛。
手机有可能成为病毒载体
既然病毒可以通过手触碰嘴巴、鼻子或眼睛来传播,我们每天平均触碰最为频繁的手机成为病毒载体就不足为奇了。
根据资料显示,早在2018年就有英国的研究机构进行过测试,分别对三款流行的手机(iPhone,Google Pixel和Samsung Galaxy),马桶座圈和抽水马桶,还有办公室的键盘和鼠标对比测试酵母、霉菌和细菌的数量,结果令人担忧。
马桶座圈和抽水马桶中的细菌含量均低于三星Galaxy和iPhone,而且所有智能手机的细菌含量均比办公室键盘和鼠标高得多。
测试还发现,智能手机屏幕上的细菌、酵母菌和霉菌含量最高,每平方厘米存在254.9单位的感染。

(△图源 - insurance2go)
而美国亚利桑那大学一项研究同样发现发现,手机中携带的细菌比大多数马桶座圈多10倍。并发现了潜在致病性微生物(金黄色葡萄球菌,不动杆菌属,假单胞菌属,蜡状芽孢杆菌和黄萎病杆菌)
所以,防范新型冠状病毒肺炎在注意洗手的同时,也应该注意手机的卫生和消毒。
据中国疾控中心消毒学首席专家张流波31日说:手怎么消毒,手机就怎么消毒。勤洗手的同时,手机也要常用酒精、消毒纸巾擦拭。此外衣物从外面回家要换下,并做清洗消毒处理,比如以56摄氏度以上的水浸泡清洗半个小时。
因为手机是我们经常用到的东西,我们在外手机的过程中或有病毒依附在表面,而我们触摸手机的时候,会将病毒转移到我们的手上,所以回到家中一定要将手机进行消毒,进而减少被病毒感染的风险。
相关文章
- 久看不累眼,护眼手机盯准这款华为畅享90系列
- 普通手机可直连卫星!海聊卫通北斗卫星徽章W1守护户外安全
- 移动电源新国标出炉,OPPO“手机级”标准打造充电宝
- 专业化→智能化→生态化,Coosea酷赛智能开启三防手机新时代
- DASUNG大上科技发布第二代墨水屏手机投屏器Link
- 全球首款手机龙虾应用线下首秀 百度RedClaw开启AI智能体沉浸式体验新场景
- 软硬件协同 三星Galaxy手机构筑隐私安全的“防护墙”
- PITAKA哈佛大学全球官方授权系列手机壳发布,以经纬编织技艺,诠释“求真”精神
- 鸿蒙商用生态再结硕果 AI工作手机赋能东风猛士重塑营销体系
- F1赛场惊现神秘新品 拯救者手机神奇新机强势回归
- 紧跟技术发展趋势 三星Galaxy手机用更主动、更个性的AI为你服务
- 中兴携系列AI终端亮相AWE2026 ,AI原生手机与AI宠物成焦点
- 追觅AURORA手机首秀AWE 三年超百亿投入致力全栈自研
- AWE抢先看:三大升级,海尔智家APP把“智慧家”装进手机
- 快易绘 2.0 全新发布|手机 · 无人机 · 手持激光“三合一“融合架构,构建快勘快撤标准化管理体系
- 一部手机看舌头,人人都是老中医,分文不花AI免费,无需久病成良医
人工智能企业
更多>>人工智能硬件
更多>>人工智能产业
更多>>人工智能技术
更多>>- 腾讯发布CodeBuddy Security,用AI Agent实现更高效的代码审计
- Twinkle x昇腾,率先实现Deepseek-V4系列模型高效训练
- 高德发布鸿蒙首个生成式 UI 开源框架 AGenUI,告别传统 UI 开发模式
- 发布即适配| 天数智芯全力支持腾讯混元Hy3 preview 开源落地,共推国内大模型产业普惠
- Seedance 2.0面向企业公测,豆包大模型日均Token使用量突破120万亿
- 端到端OCR模型第一!百度千帆Qianfan-OCR正式发布
- 云知声Unisound U1-OCR大模型发布!首个工业级文档智能基础大模型,开启OCR 3.0时代
- 基石智算上线 MiniMax M2.5,超强编程与智能体工具调用能力









